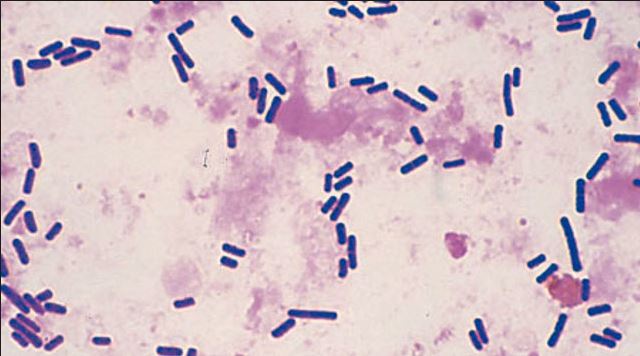
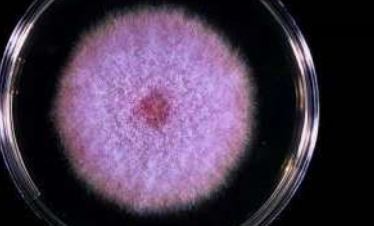
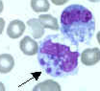
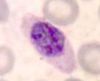
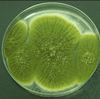
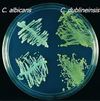
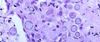
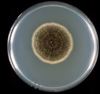
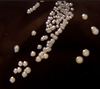
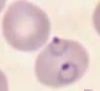
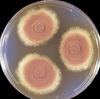
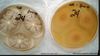
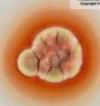
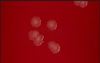
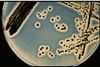
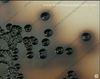
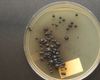
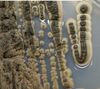
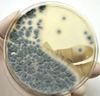
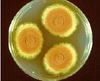
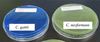

What is the most common cause of viral (aseptic) meningitis?
Enterovirus
What are the dematiaceous molds?
Fast growers: Bipolaris, Drechslera, Exserohilum, Helminthosporum, Curvularia, Alternaria, Ulocladium and Stemphilium
Slow growers: Exophialia, Wangiella, Hortaea, Pseudoallescheria boydii/Scedosporium boydii complex and Scedosporium prolificans
What is being shown here that is acquired from eating poorly cooked shellfish?

Paragonimus (lung fluke)
What rapid growing mycobacterium:
• Negative iron uptake
• Tolerant to 5% NaCl (heavy growth)
• Negative nitrate reductase
• Resistant to all standard anti-TB drugs
• Fewer drug options than M. fortuitum
– Susceptible to amikacin, cefoxitin, imipenem,
clarithromycin
– Resistant to fluoroquinolones
• Clarithromycin is the drug of choice for localized
infections, although resistant strains are emerging
M. abscessus
Explain how the different fermenters change the color of KIA/TSI slants initially and then at 24 hours (kind of a vague question but this is a paragraph in compendium and seems like good testable material).
Initially, a bacterium that ferments glucose but not lactose will produce an acidic (yellow) slant and acidic (yellow) butt. After the limited quantity of glucose is consumed, the organism will begin oxidative metabolism of proteins, which can only take place in the oxygen rich environment of the slant; this will turn the slant back to alkaline (red) by 24 hours, while the butt will remain yellow.
Therefore, when interpreting at 24 hours if the bottom is yellow and top is red, it means glucose fermenter only but if the top were yellow too it means lactose/sucrose fermenter in addition to glucose fermenter (both yellow, ferments both)
What diseases and responsible organisms are transmitted by body lice (Pediculus humanus)?

- Epidemic typhus (Rickettsia prowazekii)
- Liceborne relapsing fever (Borrelia recurrentis)
- Trench fever (Bartonella quintana)
What is the preferred lab test for Cryptococcus?
Latex antigen test
What organism is seen in the photo?

Toxoplasma gondii
The latent form is represented by slow-growing protozoa forms called bradyzoites encased in cysts with a cyst wall. Multiple basophilic dot-like parasites can be seen in cysts
What two mediums are mycobacterium spp grown in?
Lowenstein Jensen (solid medium egg based)
Middlebrook (agar based)
What is the only malaria spp to have quartan fevers (every 72 hours instead of 48 hours)?
P malariae
What parasitic organism is shown here and how can you be sure?

Entamoeba histolytica
Cannot distinguish E. histolytica/dispar unless RBCs seen in trophozoites
Erythrophagocytosis is diagnositc of histolytica cyst
Which bacterial spp produces chalky white colonies which become salmon orange pink when they mature, have a “musty basement” odor, is lysozyme resistant and has aerial hyphae?
Nocardia spp
What egg is this?

Taenia spp
What are the ampC organisms resistant to that the ESBLs are not?
The cephamycins (cefoxitin and cefotetan)
AmpC is also resistant to the beta lactamase inhibitors
Which virus causes this cytopathic effect?

HSV
RAPID (time to CPE 1-3 days), shrunken or enlarged cells starting at the edge of the cell sheet, sweeping CPE, occasional giant cells
Can be found in PMK and Hep2 (++) but grows best in HDF cells (+++)
*PMK=Primary Monkey Kidney, Hep2/HeLa=Human Epithelial Cells, HDF=Human Diploid Fibroblasts
The organism seen here on this cornmeal plate looks similar to Candida glabrata (which will not have spaces between colonies) and it is UREASE positive and produces MELANIN on bird seed agar?

Cryptococcus neoformans
Urease positive and also phenol oxidase positive
Which clostridium species is boxcar shaped and preliminary ID involves demonstrating lecithinase activity?
C. perfringens
*Double zone of beta hemolysis on blood agar

Where is the latency and what are the acute and reactivation diseases caused by:
1) HHV6
2) HHV7
3) HHV8
1) HHV 6 is dorment in T cells and causes roseola (exanthem subitum) and can be reactivated in immunocomprised
2) HHV7 is dorment in lymphocytes and causes roseola (occasionally) and can be reactivated in immunocomprised
3) HHV8 is dorment in B lymphocytes and endothelial cells and causes unknown disease acutely but reactivation causes Kaposi sarcoma and Primary Body Cavity lymphoma
Fulminant rocky mountain spotted fever can be seen in patients with what other disease?
Glucose-6-phosphatase deficiency
What antibiotics are the enterococci intrinsically resistant to?
The enterococci are intrinsically resistant to cephalosporin antibiotics, clindamycin, trimethoprim-sulfamethoxazole, and the aminoglycosides (with the exception of high-level aminoglycoside resistance screening). In vitro susceptibility testing should not be performed on enterococci for these antimicrobial agents as these agents may appear effective in vitro but are not clinically effective.
What two types of malaria DO recur from the liver?
– P. vivax – high incidence, most of the world except Western Africa
– P. ovale – lower incidence, occupies the niche in Western Africa
What are the major causes of pneumonia in the setting of animal exposure from:
1) Cattle or cats
2) Birds
3) Bat or bird droppings, especially pigeons
4) Mouse urine and feces
5) Rabbits
1) Coxiella burnetii
2) Chlamydophila psittaci and Cryptococcus neoformans
3) Histoplasma capsulatum
4) Hantavirus
5) Francisella tularensis
What organism is this?

Fusarium
Common in fungal keratitis (most commonly F. solani complex)
Macro and Microconidia
Where in the US can Mycobacterium leprae be found?
Causes leprosy (Hansen disease)
In the US, found in Hawaii, Texas and Louisiana where it is harbored by armadillos.
Cannot be cultured on artificial media. In tissue biopsy, be visualized with Fite stain